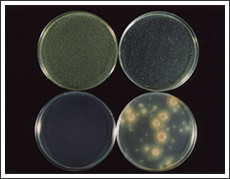
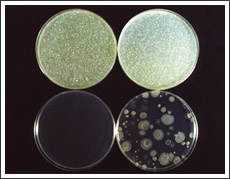

| ■ミョウバンとは? ミョウバン自体は、漬物の発色剤や麺のかんすいとして広く使われる食品添加物で、カリウムやアルミニウムなどの金属が硫酸塩の形で構成された物質の総称を言います。日本でも、漬け物の鮮やかな色をだすための生活の知恵として古くから使用される、体に安全な成分です。ミョウバンは優れた3つの作用「制菌力」「制汗力」「消臭力」があり、体臭・ワキガ臭・ワキガ臭が気になる人に生活の知恵として古くから愛用されています。 |
![]() |

制菌作用
体臭・ワキガ臭・ワキガ臭は、アポクリン腺の汗に含まれる物質を皮膚表面の雑菌が分解することで発生します。ミョウバンは水に溶けると酸性になるため、皮膚が酸性に保たれ、雑菌の繁殖が抑制、臭いが抑えられることになります。 |
制汗作用
ミョウバンには汗を抑える作用があります。詳しいメカニズムはまだ解明されていません。汗腺や角質層に働きかけているのだろうと言われています。臭いの成分の含まれた汗を抑えることで、臭いの原因をシャットアウトすることになります。 |
消臭作用
皮膚上に作られた臭い自体を消臭する作用です。臭う原因の汗の成分はアルカリ性のため、酸性であるミョウバンと化学反応を起こし、臭い成分自体を中和し消臭します。特に悪臭の1つであるアンモニアはアルカリ性でミョウバンと強く反応するため非常に有効です。 |
■さらにミョウバンには優れた収れん作用があります。
皮膚の一番外側の部分(角層)は角質というタンパク質でできています。このタンパク質にミョウバンが作用すると、収れん(引締め)作用により丈夫ですべすべした物質に変化します。すると、皮膚の防壁性が高まり、外の刺激から肌を守る働きが強くなります。 |
パーフェクトデオドラントセット(ノーマルタイプ)を使った雑菌の繁殖抑制実験(2005.01測定) 脇などのアポクリン腺から出る汗と、繁殖した雑菌が反応し独自のニオイ(ワキガ臭)が発生します。ドクターデオドラントは雑菌をしっかり減らし、繁殖を抑えることでニオイを出にくくするのです。写真の実験では、ドクターデオドラントのミョウバンせっけん・スプレーの成分を含ませたパッチを、雑菌を入れたトレーの置き3日間観測した結果、パッチを置いた部分とその周辺は全く、雑菌を繁殖させなかったという結果が出ました。雑菌を繁殖させないということは汗が出ても、独特の気になるニオイやワキガ臭は発生しないということなのです。 また、ドクターデオドラントは毛穴をふさいで汗を抑える方式ではないので、お肌に無理な負担はありません。今までの制汗剤のように色が付いたり、ベトベト感もなく、無香タイプですので汗と混じりあってさらに嫌なニオイになることもありません。お肌を常に雑菌のない清潔な状態に保ち、スプレーの後もすぐに乾きますので、使用感はいつもサラサラで、周りの人にも知られることはありません。 さらに雑菌が少ない状態に保つことで、時間をおいても雑菌の繁殖スピードが極端に遅くなり、何もケアしない状態でもニオイ(ワキガ臭)が出にくくなるのです。 |
■ワキの臭いのメカニズム アポクリン腺 からでる汗は、体内では無臭ですが、汗として体外に出され、空気や雑菌に触れることで強い臭いを発するようになります。皮膚表面の常在菌によって分解されると臭いになるのです。また、エクリン汗も雑菌によって分解されて低級脂肪酸に変わるため、酸っぱい臭いになります。
さらに、体内に乳酸がふえると、汗に含まれる尿素とアンモニアが急激に増え、強烈なアンモニア臭も発するようになります。乳酸の増える原因は、末梢血管の循環が悪くなって酸欠になったり、食事のバランスが崩れたり、ストレスが重なることにより、糖を消費する解糖系が働くためです。汗の中に乳酸が増えるとアンモニア臭の原因になってしまうのです。 |
|
![]() |
|||||
ミョウバンスプレーEXの抗菌力を、他のデオドラントと比較して、財団法人日本食品分析センターにて試験を行う。試験液に黄色ブドウ球菌及び白癬菌の菌液を添加、混合後25℃で保存し、保存1分後及び6時間後に試験液の生菌数を測定した。なお、あらかじめ予備試験を行い、生菌数の測定方法について検討した。 |
|||||
| 【試験菌】 1.黄色ブドウ球菌 2.白癬菌 【試験用培地】 NA培地:普通寒天培地 〔栄研化学株式会社〕 NB培地:普通ブイヨン培地 〔栄研化学株式会社〕 PDA培地:ポテトデキストロース寒天培地 〔栄研化学株式会社〕 GP培地:グルコースペプトン培地 〔日水製薬株式会社〕 SCDLP培地:SCDLP培地 〔日本製薬株式会社〕 GPLP培地:GPLP培地 〔日本製薬株式会社〕 SCDLPA培地:SCDLP寒天培地 〔日本製薬株式会社〕 GPLPA培地:GPLP寒天培地 〔日本製薬株式会社〕 |
![]() |
||||
![]() |
|||||
| 結果を下記グラフに示しました。 なお、試験液をSCDLP培地及びGPLP培地で10倍に希釈することにより、検体の影響を受けずに生菌数が測定できることを予備試験により確認しました。 ![]() |
|||||
| オレンジ色の線がミョウバンスプレーEX、紫色の線が比較したデオドラント、水色の線が精製水になります。黄色ブドウ球菌・白癬菌の両グラフ共に、ミョウバンスプレーEXは測定1分後には生菌数が検出されない事がわかります。なお比較したデオドラントは、測定180分後に試験菌以外の菌が検出されました。 | |||||
|
|||||
開始時及び、6時間保存後の生菌数を測定した寒天平板の一例です。 両写真とも、左下がミョウバンスプレーEXになります。写真を見ると、ミョウバンスプレーEXは菌の繁殖が抑えられている事がわかります。 |
|||||


















ミョウバンスプレーEXの抗菌力を、他のデオドラントと比較して、財団法人日本食品分析センターにて試験を行う。試験液に黄色ブドウ球菌及び白癬菌の菌液を添加、混合後25℃で保存し、保存1分後及び6時間後に試験液の生菌数を測定した。